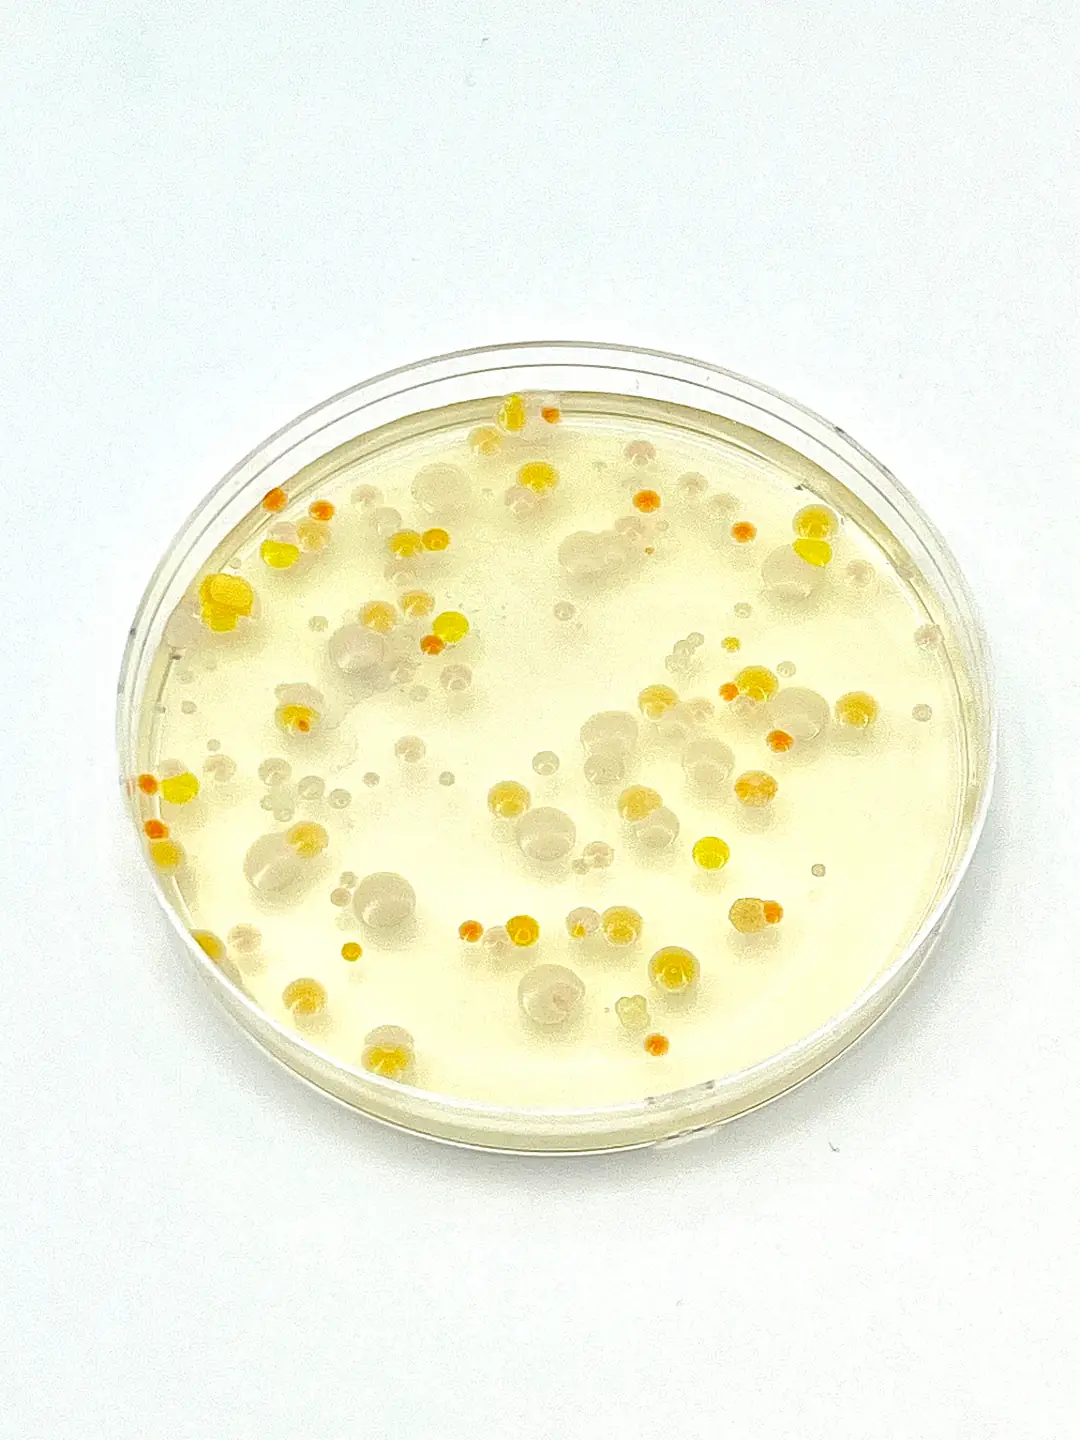
Air Plate Sampling Roesink Microbiology

If you are having a hard time accessing the How To Count Microbial Load page, Our website will help you. Find the right page for you to go to How To Count Microbial Load down below. Our website provides the right place for How To Count Microbial Load.








EXCEL COUNT
https://jingyan.baidu.com › article
EXCEL 2007 5 COUNT COUNTA COUNTBLANK COUNTIF COUNTIFS 5
Count On Me
https://jingyan.baidu.com › article
Count On Me Peter Gene Hernandez 1985 10 8 Bruno Mars
Thank you for visiting this page to find the login page of How To Count Microbial Load here. Hope you find what you are looking for!